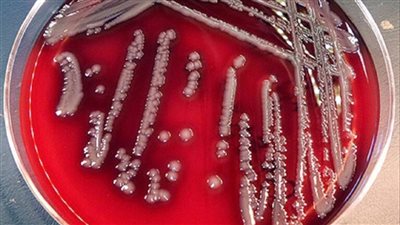
ظهور بكتيريا

عاجل
دوري كرة السلة الإفريقي يعلن الأندية الـ12 وجدول مرحلة المجموعات لموسم 2026
وادى دجلة يتوج بدرع دورى عمومى الرجال والسيدات 2025/2026 بالعلامة الكاملة بعد الفوز فى خمس مباريات وحصد 15 نقطة
رئيس جامعة أسيوط التكنولوجية يُشيد بقرار تشكيل اللجنة المؤقتة لنقابة التكنولوجيين
محافظ الجيزة يفتتح مبنى الإعدادي بمدرسة شهداء نزلة الشوبك الإعدادية المشتركة بالبدرشين بعد تطويره
تحرير 13 محضرًا تموينيًا وضبط 8 عيادات تعمل دون ترخيص في بني سويف